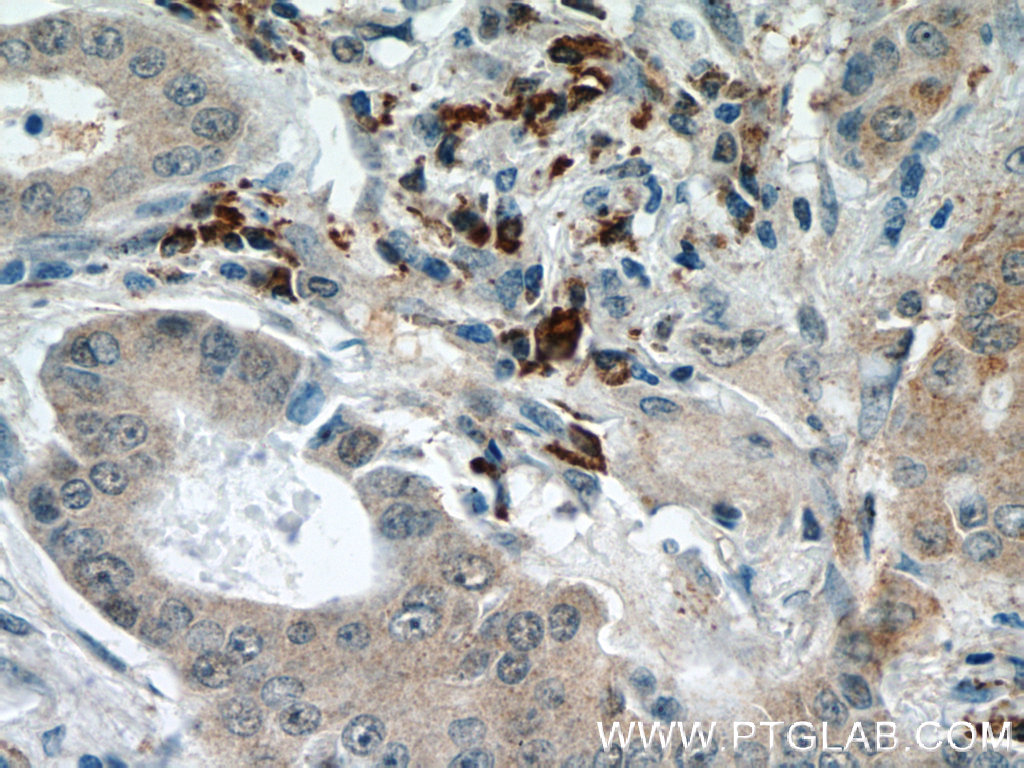

验证数据展示
经过测试的应用
| Positive WB detected in | HeLa cells, K-562 cells, HepG2 cells |
| Positive IP detected in | Jurkat cells |
| Positive IHC detected in | human testis tissue, human lung cancer tissue Note: suggested antigen retrieval with TE buffer pH 9.0; (*) Alternatively, antigen retrieval may be performed with citrate buffer pH 6.0 |
| Positive IF-P detected in | human ovary tumor tissue |
| Positive IF/ICC detected in | HepG2 cells |
| Positive FC (Intra) detected in | HepG2 cells |
推荐稀释比
| 应用 | 推荐稀释比 |
|---|---|
| Western Blot (WB) | WB : 1:200-1:1000 |
| Immunoprecipitation (IP) | IP : 0.5-4.0 ug for 1.0-3.0 mg of total protein lysate |
| Immunohistochemistry (IHC) | IHC : 1:50-1:500 |
| Immunofluorescence (IF)-P | IF-P : 1:50-1:500 |
| Immunofluorescence (IF)/ICC | IF/ICC : 1:200-1:800 |
| Flow Cytometry (FC) (INTRA) | FC (INTRA) : 0.40 ug per 10^6 cells in a 100 µl suspension |
| It is recommended that this reagent should be titrated in each testing system to obtain optimal results. | |
| Sample-dependent, Check data in validation data gallery. | |
产品信息
20567-1-AP targets DICER1 in WB, IHC, IF/ICC, IF-P, FC (Intra), IP, ELISA applications and shows reactivity with human samples.
| 经测试应用 | WB, IHC, IF/ICC, IF-P, FC (Intra), IP, ELISA Application Description |
| 文献引用应用 | WB, IHC, IF, IP |
| 经测试反应性 | human |
| 文献引用反应性 | human |
| 免疫原 |
Peptide 种属同源性预测 |
| 宿主/亚型 | Rabbit / IgG |
| 抗体类别 | Polyclonal |
| 产品类型 | Antibody |
| 全称 | dicer 1, ribonuclease type III |
| 别名 | DCR1, DICER, EC:3.1.26.3, Endoribonuclease Dicer, Helicase MOI |
| 计算分子量 | 219 kDa |
| 观测分子量 | 220-250 kDa, 90 kDa |
| GenBank蛋白编号 | NM_030621 |
| 基因名称 | DICER1 |
| Gene ID (NCBI) | 23405 |
| RRID | AB_10694287 |
| 偶联类型 | Unconjugated |
| 形式 | Liquid |
| 纯化方式 | Antigen affinity purification |
| UNIPROT ID | Q9UPY3 |
| 储存缓冲液 | PBS with 0.02% sodium azide and 50% glycerol, pH 7.3. |
| 储存条件 | Store at -20°C. Stable for one year after shipment. Aliquoting is unnecessary for -20oC storage. |
背景介绍
DICER1, also named as DICER, HERNA and KIAA0928, belongs to the helicase family and Dicer subfamily. It is required for formation of the RNA induced silencing complex (RISC). DICER1 is a component of the RISC loading complex (RLC), also known as the micro-RNA (miRNA) loading complex (miRLC), which is composed of DICER1, EIF2C2/AGO2 and TARBP2. Within the RLC/miRLC, DICER1 and TARBP2 are required to process precursor miRNAs (pre-miRNAs) to mature miRNAs and then load them onto EIF2C2/AGO2. EIF2C2/AGO2 bound to the mature miRNA constitutes the minimal RISC and may subsequently dissociate from DICER1 and TARBP2. DICER1 cleaves double-stranded RNA to produce short interfering RNAs (siRNAs) which target the selective destruction of complementary RNAs. The antibody is specific to DICER1. The calcualted molecular weight of DICER1 is 219 kDa, but modified DICER1 is about 220-250 kDa. DICER1 exists some isoforms with molecular weight 219 kDa and 93 kDa.
实验方案
| Product Specific Protocols | |
|---|---|
| FC protocol for DICER1 antibody 20567-1-AP | Download protocol |
| IF protocol for DICER1 antibody 20567-1-AP | Download protocol |
| IHC protocol for DICER1 antibody 20567-1-AP | Download protocol |
| IP protocol for DICER1 antibody 20567-1-AP | Download protocol |
| WB protocol for DICER1 antibody 20567-1-AP | Download protocol |
| Standard Protocols | |
|---|---|
| Click here to view our Standard Protocols |
发表文章
| Species | Application | Title |
|---|---|---|
Neuron Astrocytic ApoE reprograms neuronal cholesterol metabolism and histone-acetylation-mediated memory.
| ||
Nat Chem Biol Differential roles of human PUS10 in miRNA processing and tRNA pseudouridylation. | ||
Nat Commun RNA structure probing reveals the structural basis of Dicer binding and cleavage. | ||
Nucleic Acids Res HSP90 and Aha1 modulate microRNA maturation through promoting the folding of Dicer1. | ||
Nat Commun Long non-coding RNA GAS5 controls human embryonic stem cell self-renewal by maintaining NODAL signalling. | ||
J Pathol Cancer-associated somatic DICER1 hotspot mutations cause defective miRNA processing and reverse-strand expression bias to predominantly mature 3p strands through loss of 5p strand cleavage.
|